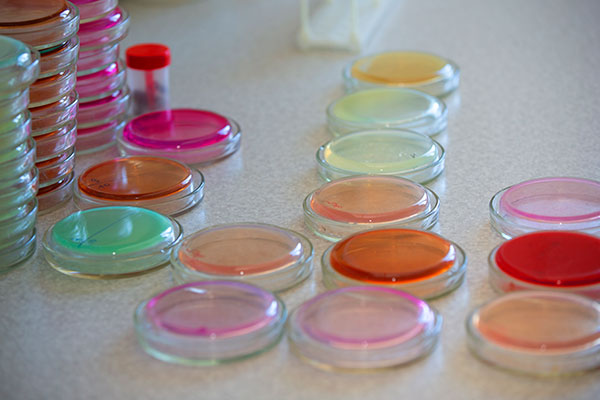

Características de la bacteria
- Se elimina a temperaturas tradicionales de cocción.
- Crece en presencia o ausencia de aire.
- Crece mejor a temperatura del cuerpo humano, y no crece por encima de los 46°C.
- Crece muy poco a temperaturas de refrigeración.
- A diferencia de otros patógenos, puede crecer a un pH tan bajo como 3.7
Sintomatología de la enfermedad
Salmonelosis : Náuseas, vómitos, calambres abdominales, diarrea, fiebre, dolor de cabeza.
Fiebre tifoidea: Fiebre alta, letargo, síntomas gastrointestinales (dolor abdominal y diarrea), dolor de cabeza, dolores musculares, pérdida de apetito. En ocasiones se presenta una erupción de manchas en la piel de color rosado.
El tracto digestivo de los animales es la fuente primaria de Salmonella. En consecuencia, productos animales crudos (carne de res y de puerco, huevos, productos lácteos) son frecuentemente asociados a brotes de enfermedad.
Existen dos especies del género Salmonella spp que pueden causar enfermedad en los seres humanos: Salmonella enterica (la de mayor preocupación para la salud pública) y Salmonella bongori.
Salmonella enterica cuenta con 2610 diferentes serotipos (clasificación de acuerdo al tipo de antígeno presente en la membrana de la bacteria, el cual es responsable de desencadenar la formación de anticuerpos y puede causar una respuesta inmune).
La fiebre tifoidea es causada por la ingestión e invasión intestinal por un serotipo específico de Salmonella enterica, el serovar Typha (S. typha).
Algunos casos severos de infección con Salmonella resultan en artritis reactiva.
Una persona que ha sufrido de salmonelosis, si no recibe un tratamiento adecuado puede convertirse en portador crónico, es decir, no presentar síntomas clínicos de la enfermedad, sin embargo, albergar el agente infeccioso y ser fuente de contagio.
Salmonella spp sobrevive muy bien en alimentos congelados y en alimentos secos.
Además de los alimentos, también podemos encontrar Salmonella spp en otras fuentes ambientales como son: el agua, el suelo, los insectos, superficies de las instalaciones (paredes, techos, mesas, etc.) y las heces de animales, entre otros. Se ha demostrado que sobrevive en la punta de los dedos hasta 80 minutos.
Debido a que Salmonella spp sobrevive en diversos ambientes, muchos otros alimentos han sido asociados a brotes de enfermedad como son: coco, salsas, harina para pastel, postres rellenos de crema, gelatina, productos con cacahuate, chocolate y cocoa e ingredientes con soya.
Se ha encontrado que ciertos serotipos de Salmonella spp viven hasta 63 días en lechuga, 231 días en perejil, 32 semanas en nueces, 10 meses en queso cheddar refrigerado, 9 meses en mantequilla, hasta 63 días en yogurt congelado y hasta 20 semanas en carne de res y pollo picada congelada.
Frutas frescas, vegetales y nueces pueden ser contaminadas durante su cultivo si no se aplican buenas prácticas agrícolas. La principal contaminación se da por cultivos regados con aguas residuales contaminadas.
Medidas de control
Las 4 principales recomendaciones que hace la Organización Mundial de Salud OMS para controlar la contaminación de los alimentos con Salmonella spp son las siguientes:
- Cocción completa
- Lavado de manos
- Separar los alimentos crudos de los alimentos cocidos
- Mantener los alimentos a la temperatura correcta de refrigeración (< 4ºC)